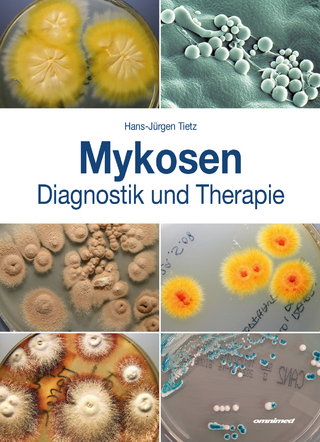
Mykosen - Tietz Hans-Jürgen

Basiswissen Palliativmedizin
Springer Berlin (Verlag)
978-3-642-19411-5 (ISBN)
- Titel ist leider vergriffen;
keine Neuauflage - Artikel merken
Das Lehrbuch geht dabei sowohl auf medizinische als auch auf ethische, rechtliche und soziale Aspekte ein. Der Leser erhält Anleitung zur Kommunikation mit Patienten und Angehörigen, zur Teamarbeit mit Kollegen aus anderen Bereichen wie z. B. Pflege, Psycho- oder Musiktherapie ebenso wie zu speziellen Themen wie Kinder- und Jugendliche am Lebensende und integrativer Palliativversorgung. In allen Bereichen kommt der Interprofessionalität eine besondere Bedeutung zu. Die Autoren geben mit Fragenkatalogen, Ausschnitten aus Patienteninterviews und Leitfäden wertvolle Anregungen und Hilfen.
Prof. Dr. phil. Martin Schnell, Direktor des Instituts für Ethik und Kommunikation im Gesundheitswesen, Witten. Dr. med. Christian Schulz, Interdisziplinäres Zentrum für Palliativmedizin (IZP), Universitätsklinikum Düsseldorf
I Einleitung: Eine kurze Geschichte der Palliativmedizin.- Interdisziplinäre Teamarbeit als Ausgangspunkt für Palliativmedizin.- Der Mensch als sterbliches Wesen und die Diversität am Lebensende.- II Der Patient und seine Symptome: Der Patient - Einführung.- Palliativmedizinisches Basisassessment.- Testinstrumente in der Palliativmedizin.- Grundlagen des Symptommanagements.- Pharmazie in der Palliativmedizin.- Symptome in der Palliativmedizin: Fatigue.- Schmerz.- Appetitlosigkeit.- Ernährung.- Übelkeit und Erbrechen.- Dyspnoe.- Husten.- Obstipation.- Obstruktion/Ileus.- Diarrhoe.- Angst/Panikattacken.- Depression.- Verwirrtheit/Delir.- Epileptischer Anfall.- Wunden.- Juckreiz.- Mundpflege.- Durst/Flüssigkeitsgabe.- Finalphase.- Notfälle in der Palliativmedizin.- III Kommunikation und Interaktion: Überbringer schlechter Nachrichten.- Kommunikation mit Sterbenden.- Existentielle Phänomene am Lebensende auf Seiten des Arztes und des Patienten.- Familienzentrierte Medizin, Angehörige.- Diversität, Sinn, Trauer und Spiritualität.- Humor in der Palliativmedizin.- IV Ethik, Interprofessionalität, System: Ethik und Recht.- Interprofessionalität.- Palliativmedizin im gesellschaftlichen System.- V Besondere Felder der Palliativmedizin: Kinder und Jugendliche am Lebensende.- Der alte Mensch am Lebensende.- Integrative Palliativversorgung - soziale Exklusion: Behinderung, Psychiatrie, Forensik am Lebensende.- Anhang
| Erscheint lt. Verlag | 22.11.2011 |
|---|---|
| Reihe/Serie | Springer-Lehrbuch |
| Sprache | deutsch |
| Maße | 127 x 190 mm |
| Gewicht | 327 g |
| Einbandart | Paperback |
| Themenwelt | Medizin / Pharmazie |
| Schlagworte | Ethik • Palliativmedizin • Palliativversorgung • Schmerztherapie • Sterben |
| ISBN-10 | 3-642-19411-7 / 3642194117 |
| ISBN-13 | 978-3-642-19411-5 / 9783642194115 |
| Zustand | Neuware |
| Informationen gemäß Produktsicherheitsverordnung (GPSR) | |
| Haben Sie eine Frage zum Produkt? |
aus dem Bereich